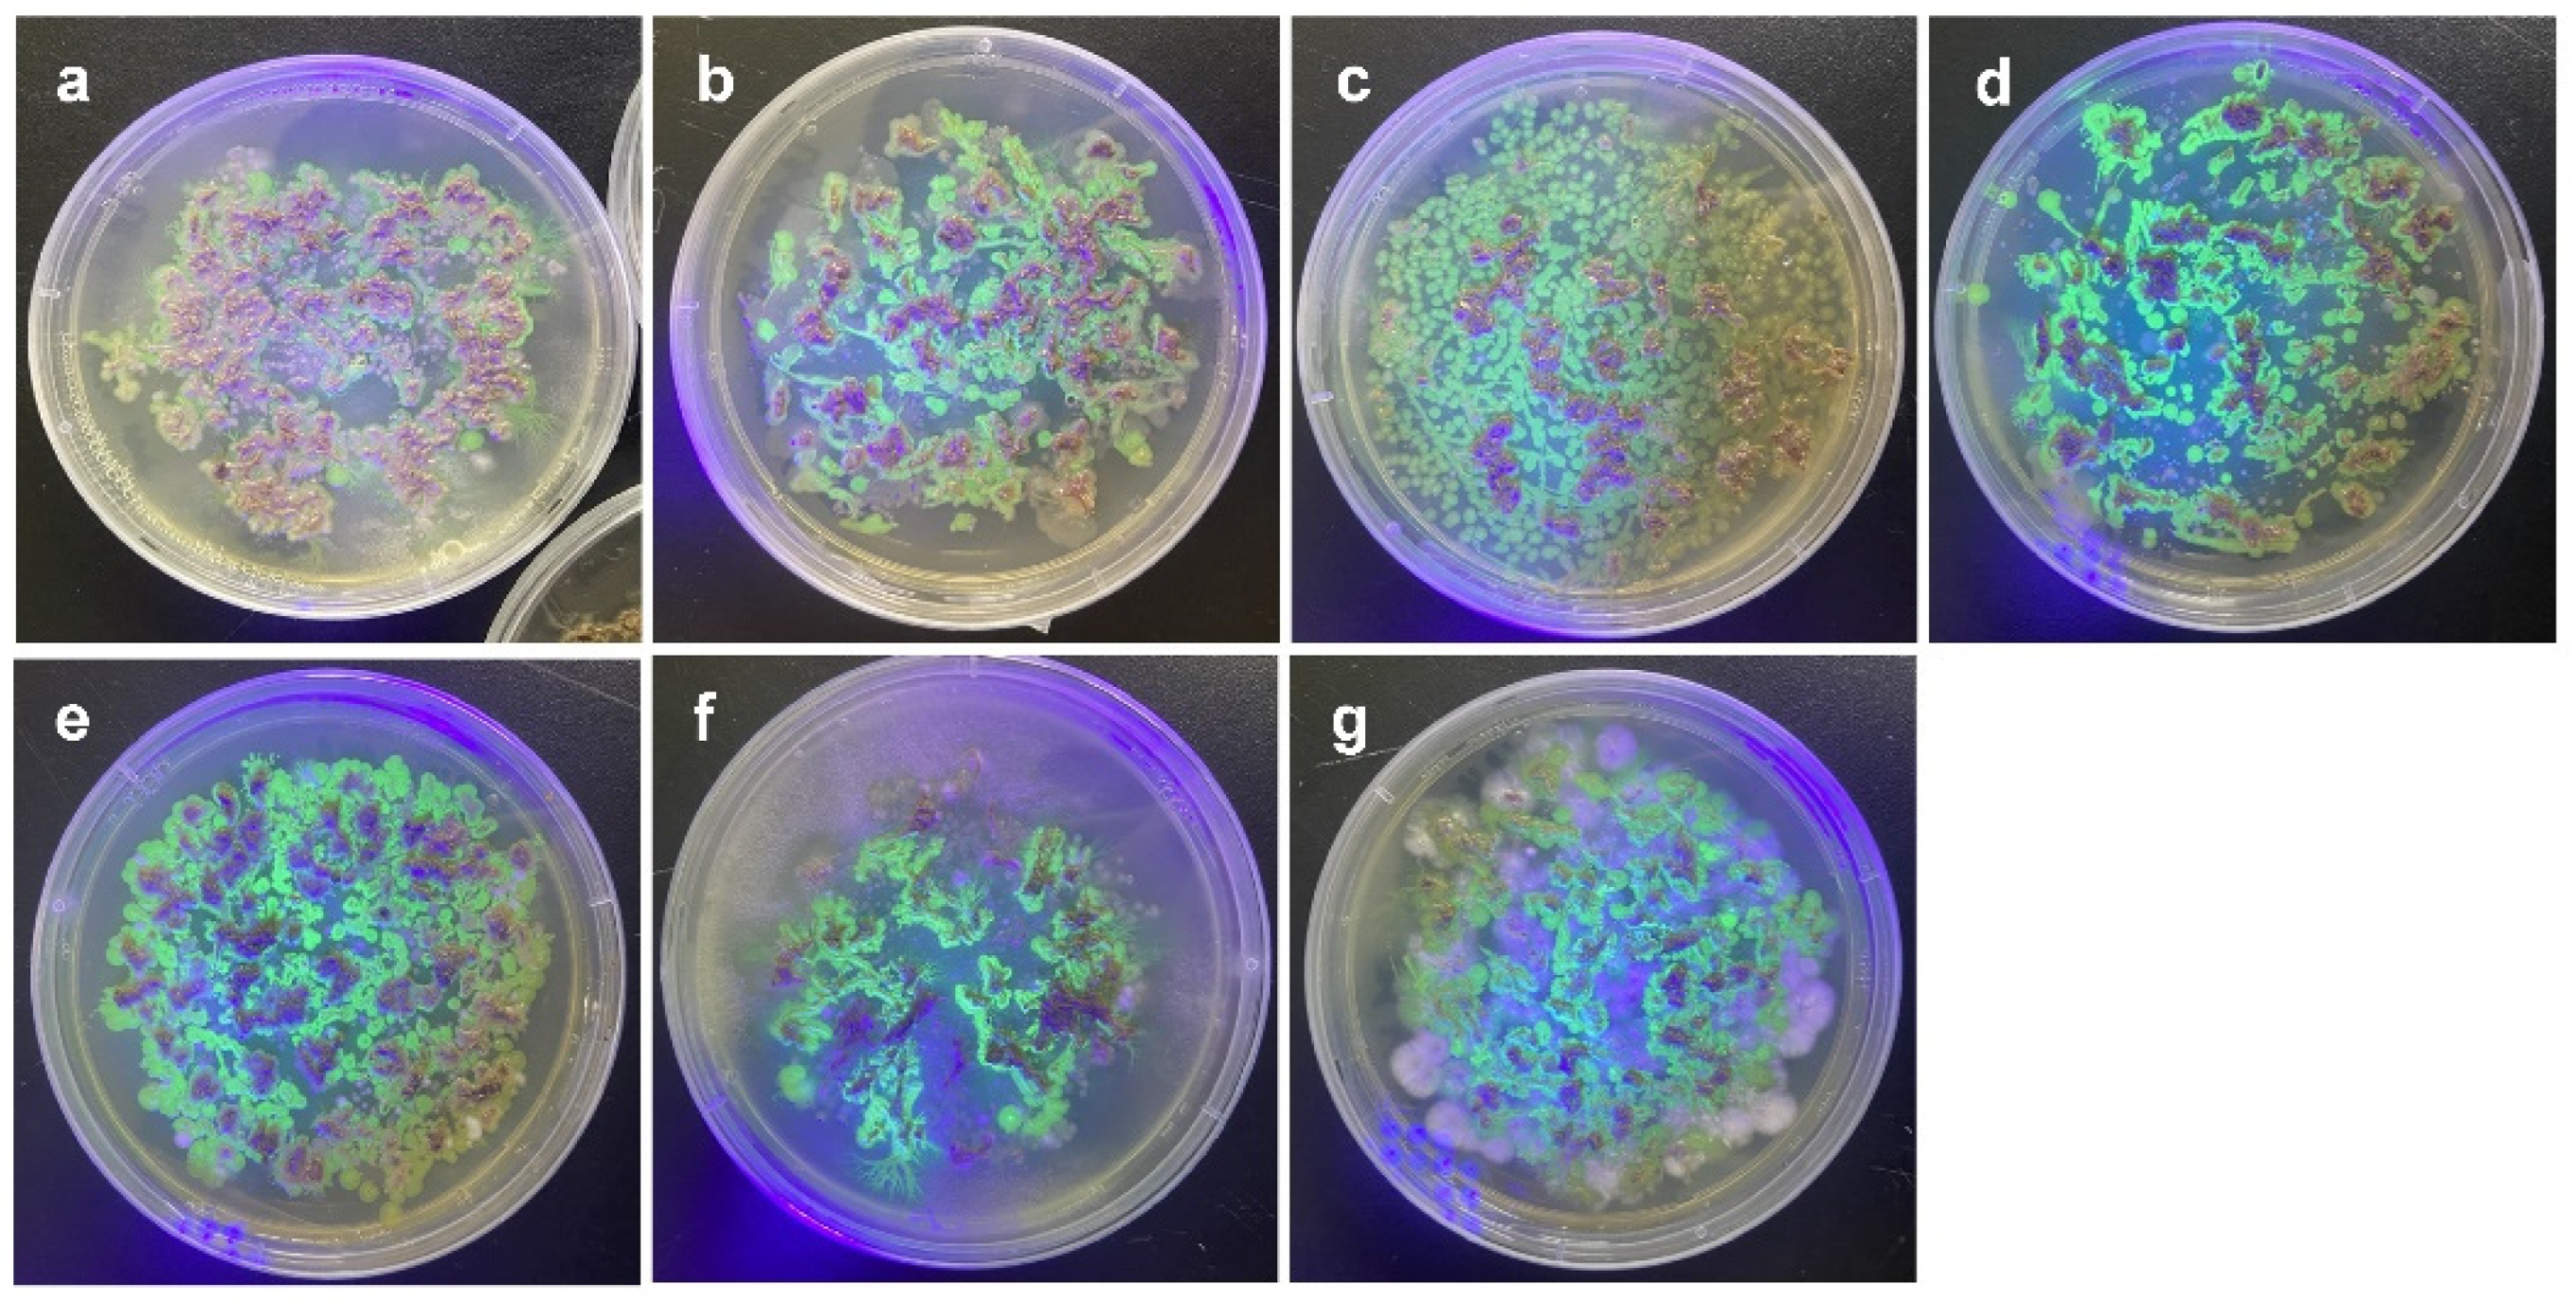
Microorganisms 10 01604 g002

Abstract
Recent studies have demonstrated that seed-borne bacteria can enhance the performance of invasive plants in novel introduced habitats with environmental stresses. The effect of this plant-bacteria interaction may vary with plant species or even genotype; however, the genotype-dependent effects of seed bacteria have rarely been assessed. In this study, we examined the effects of bacterial strains isolated from seeds on the genotypes of an invasive xerophytic plant, Lactuca serriola. Plant genotypes were grown under drought conditions, and their plastic responses to bacterial infections were evaluated. Some genotypes produced more biomass, whereas others produced less biomass in response to infection with the same bacterial strain. Notably, the quantity of root-adhering soil depended on the bacterial treatment and plant genotypes and was positively correlated with the plastic responses of plant performance. Because tested bacteria could colonize the plant rhizosphere, bacterial infection appears to induce the differential formation of soil rhizosheaths among plant genotypes, consequently affecting the maintenance of soil water content under drought conditions. Given that drought tolerance is a critical attribute for the invasive success of L. serriola, these results imply that bacterial symbionts can facilitate the establishment of alien plant species, but their effects are likely genotype-specific.
1. Introduction
Plant-associated microbes have been suggested to constitute plant holobiomes and influence plant development and growth [1,2]. Plants can benefit from microbes that assist in nutrient acquisition or produce exogenous phytohormones [3,4]. In addition, plant growth-promoting (PGP) microbes can protect the host plant from abiotic stresses by diverse stress ameliorating mechanisms [5,6].
Recent studies have proposed that PGP microbes can contribute to the invasive capability of exotic plant species [7,8,9]. They can alleviate biotic and abiotic stresses in newly arrived habitats, and consequently, stimulate plant establishment and competitive ability. Among plant-associated microbes, endophytic bacteria residing inside the seeds are of particular interest. Because seeds and microbes would move together to the new habitat, seed bacteria can provide an advantage to invasive plants regardless of the existence of mutualistic microbes in the introduced sites [10]. In addition, seed endophytes are expected to be transmitted vertically to their offspring; hence, their effects can be present for generations [11].
A xerophytic invasive plant, Lactuca serriola (Asteraceae), has rapidly expanded its geographic range in South Korea since its first report in 1978 [12]. In a previous study, bacteria were isolated from the seeds of L. serriola, and their drought stress-ameliorating effects were evaluated in a model plant species, Arabidopsis thaliana [10]. The bacterial isolates grew vigorously under high osmotic pressure, indicating that they could tolerate drought stress. One strain out of the 12 isolates, Kosakonia cowanii GG1, stimulated the growth of A. thaliana under drought stress. However, the mutualistic interaction between plants and bacteria tends to depend on the host plant species [13,14]. Thus, the effects of isolated bacteria on plant performance should be examined in L. serriola host plants to evaluate their ecological significance in terms of invasiveness.
Bacteria producing exopolysaccharides have been demonstrated to alter soil characteristics, consequently ameliorating drought stress. Bacterial exopolysaccharides can contribute to soil aggregation and water retention around plant roots [10,15]. In addition, exopolysaccharides can induce a firm adherence of soil to the roots, which is referred to as the rhizosheath. A thick rhizosheath can alleviate drought stress by securing soil water [16,17]. In A. thaliana, K. cowanii GG1 can colonize in the root and produce a relatively high amount of exopolysaccharides when grown in media with a negative water potential. Based on these observations, the production of exopolysaccharide by K. cowanii GG1 was suggested to promote the drought tolerance of A. thaliana. A similar mechanism might occur in L. serriola.
Similar to species-specific responses to endophytic bacteria, plant genotypes may also respond differently to endophytic bacteria. The role of plant genotypes in shaping seed microbiome has been well-established, suggesting that plant-endophyte interaction is possibly dependent on plant genotypes [18,19]. However, few studies explicitly assessed the responses of multiple plant genotypes to bacterial treatments and the information about genotype-specificity is still inconclusive [20,21,22]. From an evolutionary ecological perspective, characterizing plant genetic variation in response to endophytic bacteria is of interest because the variation indicates that the fitness difference among plant genotypes probably depends on the existence of endophytic bacteria.
In this study, we inoculated the previously isolated seed endophytic bacteria into their original host, L. serriola, and evaluated whether the isolates alleviated drought stress in the host plant. In particular, we assessed the plastic responses of five maternal genotypes of L. serriola to bacterial infection under drought stress to examine genotype-specific responses to bacterial treatments. Bacterial strains transformed with a plasmid containing green fluorescent protein (GFP) gene were used to confirm colonization by the bacterial isolates. Effects of bacterial inoculation on soil characteristics were also assessed, including the quantity of root-adhering soil and its polysaccharide content.
Specifically, we addressed the following questions: (1) Do the genotypes of L. serriola exhibit differential plastic responses to the infection of seed bacteria under drought conditions? (2) Do the infection of seed bacteria and plant genotypes influence soil characteristics? (3) Does the plant performance under drought conditions correlate with soil characteristics?
2. Materials and Methods
2.1. Preparation of Isolates Transformed with a Plasmid Containing GFP for the Infection into Seeds
To confirm whether the isolates colonized the plants, ten isolates (Pantoea septica YJ1, Kosakonia cowanii YJ4, Erwinia tasmaniensis YJ6, K. cowanii SD1, P. ananatis SD16, P. dispersa SD25, Cronobacter dublinensis subsp. dublinensis MS24, C. dublienesis subsp. lausanneisis MS26, K. cowanii GG1, and P. ananatis GG19) from a previous study were subjected to transformation with a broad host range plasmid pDSK-GFPuv (#PVT12964, Nova Lifetech, Singapore) containing GFPuv protein and kanamycin resistance gene for selection [10,23]. The plasmid was amplified using chemically competent Escherichia coli DH5a (#CP011, Enzynomics, Daegeon, Korea) cells that were transformed using the heat-shock method and then extracted from the cells using the QIAprep Spin Miniprep Kit (#27106, Qiagen, Hilden, Germany). Electrocompetent cells were prepared following the manufacturer’s instructions using a MicroPulser (#165-2100, Bio-Rad Laboratories, Hercules, CA, USA). The pDSK-GFPuv plasmid (2 µL) was injected into 40 µL of electrocompetent cell suspension using a MicroPulser with a 0.1 cm electroporation cuvette (#165-2089, Bio-Rad). A pulse of 1.8 kV voltage at 5 ms intervals was applied. After recovery in Luria–Bertani (LB) broth (#244620, BD Difco, Franklin Lakes, NJ, USA) at 37 °C for 1 h, the transformed colonies were selected on LB agar (#244520, BD Difco) medium containing kanamycin (50 µg/mL) and stored at −80 °C.
2.2. Experimental Design
The seeds of five maternal genotypes of L. serriola collected from Bongsan-ro, Cheongju-si, South Korea (latitude: 36.620556, longitude: 127.328611), were used. Seed surfaces were sterilized by soaking the seeds in 3% sodium hydrochloride for 3 min. Seeds were inoculated with the ten isolates by immersing them overnight in a bacterial suspension (108 CFU mL−1) containing phosphate-buffered saline (PBS) [24]. Seeds submerged in PBS were used as controls. The GFP-transformed isolates were used to confirm bacterial infection after harvesting.
Seeds were sown in trays with 105 holes with sterile commercial soil and watered daily. Twenty-five days after sowing, six seedlings of each maternal genotype were randomly chosen in each bacterial treatment. A single seedling was transplanted into a pot (8 cm × 7.5 cm × 6 cm) containing sterile vermiculate (Green Fire Chemicals, Hongseong, Korea) and sand (Glpark, Seoul, Korea) in a ratio of 3:1 (volume) [25]. Because most of the seeds inoculated with P. ananatis SD16, P. dispersa SD25, and C. dublinensis subsp. dublinensis MS24 failed to germinate, they were excluded from further experiments. This resulted in a total of 240 seedlings for the drought treatment (eight bacterial treatments including negative control × five maternal genotypes × six replicates).
The pots were placed in a walk-in chamber, following a completely randomized design, maintained at 22 °C under a 12/12 h light/dark photoperiod throughout the experiment. Deionized water was applied on alternative days, and the Hoagland’s solution (1.25 mM KNO3, 1.5 mM Ca(NO3)2, 0.75 mM MgSO4, 0.5 mM KH2PO4, 0.05 mM H3BO3, 0.01 mM MnCl2, 0.002 mM ZnSO4, 0.0015 mM CuSO4, 0.075 μM NH4Mo7O24, and 0.074 mM Fe-EDTA) was applied once a week to ensure nutrient supply [25]. Drought treatment was applied 42 d after sowing and maintained for 13 days. Among the six plants of each maternal genotype in each bacterial treatment, four plants were subjected to drought conditions by stopping their water supply, and the remaining two plants were watered regularly to confirm the effects of the drought treatment. Five individuals in the uninoculated control accidentally died during the maintenance period of transplanted seedlings and drought treatment. Thus, two plants were watered regularly, and two to four plants were imposed under drought conditions in each maternal genotype and each bacterial treatment. The sample size for each bacterial treatment and plant genotype is given in Table S1.
2.3. Plant Trait Measurements
After 13 d of drought treatment, the plants were harvested for trait measurements. The shoot and root fresh weights were measured immediately after harvesting. The roots were dried in a drying oven (Hanbaek Co. Ltd., Anyang-si, Kyunggi-do, Korea) at 70 °C for 72 h for dry weight measurements [26]. To confirm the colonization of the infected isolates in the plant rhizosphere, five out of twenty plants in each bacterial treatment under drought stress were randomly selected. Root tissues of these plants were pooled together, cut into small pieces using sterilized scissors, and placed on LB agar medium containing kanamycin (50 µg/mL). The plates were incubated at 28 °C, and GFPuv-expressing bacterial colonies were observed under UV light.
To evaluate the effects of bacterial treatment on the physiological responses of plants to drought stress, we measured the relative water content (RWC) and malondialdehyde (MDA) content in the leaves. In response to drought, the RWC of plants has been known to decrease and the MDA content in leaves has been known to increase due to oxidative damage to membrane lipids. The RWC in one leaf was determined by calculating the difference between the fresh weight and dry weight, which was measured after drying the leaf in a drying oven at 70 °C for 72 h, divided by the difference between the fresh weight and turgid weight, which was measured after submerging the leaf in deionized water for 24 h at 4 °C [27]. The MDA content in leaf tissue (0.1 g), which was stored at −80 °C immediately after harvesting, was measured using thiobarbituric acid reactive substances (TBARS) assay [28,29]. The leaves were ground using TissueLyser II (QIAGEN) and homogenized using 1 mL of 0.1% (w/v) trichloroacetic acid (TCA, T6399, Sigma-Aldrich, St. Louis, MI, USA). After centrifugation, the supernatant was mixed with 4 mL of 20% TCA containing 0.5% thiobarbituric acid (T5500, Sigma-Aldrich), and the mixture was boiled at 95 °C for 15 min. The absorbance of the solution was measured at 532 nm using the BioSpectrometer basic (Eppendorf, Hamburg, Germany).
2.4. Soil Characteristics
Three soil characteristics were examined to determine the bacterial effects. The gravimetric soil water content was measured as the difference between the weight of the soil at harvest and the weight of the soil after drying at 105 °C for 72 h. Root-adhering soil (RAS) was collected in a conical tube by washing the roots with ddH2O after gentle shaking and air-drying. The soil (5 mg) was transferred to another tube, and the concentration of soil polysaccharides was measured using the direct determination method as previously described [30]. The dry weight of the RAS was measured after drying at 105 °C for 72 h.
2.5. Visualization of GFP-Transformed Isolates Using Confocal Microscopy
Seeds of genotypes one (P1) and five (P5) were infected with GFPuv-transformed bacterial isolates as described previously and then sown on Murashing and Skoog medium (M0222.0050, DUCHEFA, Haarlem, The Netherlands) containing 1.5% Bacto Agar (214010, BD Difco). After germination, the roots of seedlings were fixed with 4% paraformaldehyde (158127, Sigma-Aldrich) for 120 min, and then washed twice with PBS solution [31]. To eliminate autofluorescence from plant tissue, the samples were soaked in ClearSee solution (10 % (w/v) xylitol powder, 15 % (w/v) sodium deoxycholate, 25 % (w/v) urea; 1.410 refractive index) for 1 week. Thereafter, the samples were stained using calcofluor white (18909, Sigma-Aldrich) for 30 min, followed by washing with the ClearSee solution for 30 min [32]. The samples were observed under a FV3000RS confocal laser scanning microscope (CLSM) with a UPLSAPO 30× silicon lens (Olympus, Tokyo, Japan). The images were taken using the z-stack method at 0.620 µm intervals. Calcofluor white signal was measured at 461 nm emission with 405 nm excitation, whereas the GFPuv signal was measured at 513 nm emission with 488 nm excitation.
2.6. Statistical Analyses
All statistical analyses were performed using R software 4.0.1 (R Foundation for Statistical Computing, Austria). A mixed-model analysis of covariance (ANCOVA) was performed to confirm the effect of drought treatment on plant performance. Drought treatment was a fixed factor, and maternal genotype and bacterial treatment were random factors. Leaf length at transplanting was included as a covariate to control the influence of plant size on the effect of drought treatment.
A subset of the entire dataset, including pots with drought treatment, was constructed to examine plant responses to bacterial treatments under drought conditions. The relative distance plasticity index (RDPI) is well-acknowledged as an appropriate measure for comparing differential plastic responses to treatments among plant genotypes [33]. We adopted this method and calculated the RDPI of the bacterial treatments for each plant genotype. First, the relative distances of trait values were calculated as differences in trait values divided by the sum of trait values between all pairs of individuals in the different bacterial treatments. The RDPI of the bacterial treatment was measured as the average of the relative distances between the control and each bacterial infection. For calculating the relative distance, the difference in trait values was used instead of the absolute values of the difference to consider the direction of plastic responses. The number of data points ranged from eight to sixteen for each bacterial treatment and each plant genotype.
Two-way analyses of variance were conducted to compare the RDPI of bacterial treatments among plant genotypes. The model comprised bacterial treatment, plant genotype, and their interactions as fixed factors. Tukey’s post hoc multiple comparison tests were conducted for each bacterial treatment to interpret the interactions between bacteria and plant genotypes.
3. Results
In response to drought treatment, plants exhibited reduced shoot (F1,309 = 476.15, p < 0.001) and root (F1,310 = 336.68, p < 0.001) fresh weights and root dry weight (F1,262 = 27.73, p < 0.001) compared with those in the control (Figure 1). RWC in leaves decreased (F1,318 = 242.38, p < 0.001) and MDA content in leaves increased (F1,317 = 275.53, p < 0.001) in response to the drought treatments (Figure 1). Drought treatment decreased the soil water content by at least 16%.
Figure 1.
Effects of drought treatment on plant traits and soil characteristics Average values and standard errors of (a) shoot fresh weight, (b) root fresh weight, (c) root dry weight, (d) relative water content in leaves, (e) MDA contents in leaves, (f) soil water contents, (g) soil polysaccharide concentration, and (h) root-adhering soil are given.
Bacterial colonies with fluorescence were observed when the roots of the plants were incubated on agar plates (Figure 2). When two plant genotypes (P1 and P5) were infected by the bacterial strains, colonized bacteria were observed inside and on the surface of the roots (Figure 3 and Figure S1).
Figure 2.
Observation of GFPuv-expressing colonies isolated from bacteria-treated root tissues under UV lamp. (a) Pantoea septica YJ1, (b) Kosakonia cowanii YJ4, (c) Erwinia tasmaniensis YJ6, (d) K. cowanii SD1, (e) C. dublienesis subsp. lausanneisis MS26, (f) K. cowanii GG1, (g) P. ananatis GG19.
Figure 3.
Images of the root tissues of Lactuca serriola genotype P1 with GFPuv-transformed isolates using confocal microscopy. The plant cell wall and isolates are indicated by red and green, respectively. (a) Uninfected control, (b) Pantoea septica YJ1, (c) Kosakonia cowanii YJ4, (d) Erwinia tasmaniensis YJ6, (e) K. cowanii SD1, (f) C. dublienesis subsp. lausanneisis MS26, (g) K. cowanii GG1, (h) P. ananatis GG19. Scale bar: 50 µm.
L. serriola genotypes exhibited differential plastic responses to bacterial treatments for all measured plant traits when grown under drought conditions, as indicated by the significant interactions between the genotype and bacterial treatment (Table 1). Plant genotype P3 exhibited positive RDPIs for shoot fresh weight, root fresh weight, and root dry weight in response to all bacterial treatments, except P. ananatis GG19 (Figure 4). In addition, genotypes P2, P4, and P5 showed positive RDPIs with E. tasmaniensis YJ6, K. cowanii YJ4, and P. ananatis GG19, respectively, for the shoot and root biomass (Figure 4). The positive RDPIs indicate that plants infected by bacterial isolates produced higher shoot and root biomass than the control plants. In contrast, negative RDPIs of root and shoot biomass were found for the P1 and P5 genotypes infected by E. tasmaniensis YJ6, C. dublienesis MS26, K. cowanii SD1, or K. cowanii GG1, indicating that these plants produced less biomass than the control plants under drought conditions (Figure 4). Bacterial treatments that resulted in positive RDPIs for plant biomass tended to cause positive RDPIs for leaf RWC and negative RDPIs for leaf MDA content (Figure 4). The positive RDPIs for MDA content indicate that drought stress increased the oxidative damage to membrane lipids.
Table 1.
Results of analysis of variance comparing relative distance plasticity index (RDPI) among plant genotypes in response to bacterial treatments under drought conditions. F ratios are given. * p < 0.05, ** p < 0.01, *** p < 0.001.
Figure 4.
Plastic responses of different Lactuca serriola genotypes to bacterial treatments. Average relative distance plasticity indexes (RDPIs) and standard errors of (a) shoot fresh weight, (b) root fresh weight, (c) root dry weight, (d) relative water contents, and (e) MDA contents are presented. Letters indicate statistically significant (p < 0.05) differences among genotypes based on Tukey’s multiple comparison tests. The names of bacterial strains are given in Figure 1.
The RDPIs for the measured soil characteristics exhibited a pattern similar to that of the RDPIs for plant biomass. Pot soil with plants exhibiting positive RDPIs for biomass tended to have positive RDPIs for RAS and soil water content (Figure 5). In addition, the RDPIs for soil water, RAS, and plant biomass production were positively correlated as determined by the Pearson’s correlation analysis (Figure 6). The RDPIs for polysaccharide concentration were not correlated with the RDPIs for the other measured traits.
Figure 5.
Plastic responses of different Lactuca serriola genotypes to bacterial treatments. Average relative distance plasticity indexes (RDPIs) and standard errors of (a) soil water contents, (b) soil polysaccharide concentration, and (c) root-adhering soil are presented. Letters indicate statistically significant (p < 0.05) differences among genotypes based on Tukey’s multiple comparison tests. The names of bacterial strains are given in Figure 1.
Figure 6.
Correlogram of Spearman’s correlation coefficients between RDPIs of plant traits and soil characteristics. Negative correlations are in red and positive correlations are in blue. *** p < 0.001.
4. Discussion
Bacterial strains isolated from the seeds of invasive L. serriola could colonize the rhizosphere of their original host. When plants were grown under drought conditions, plant genotypes exhibited differential plastic responses to bacterial treatments, indicating that the effects of bacterial infection on plant performance depend on the plant genotype.
4.1. Genotype-Specific Responses to Bacterial Infection
In plant genotype P3, six out of seven tested bacterial strains stimulated the shoot and root biomass of plants under drought stress. They increased RWC and reduced MDA content in leaves, indicating that they ameliorated the drought stress imposed on plants. Similar to this study, inoculation of the endophytic bacterium C. dublinensis strain MKS-1 in pearl millet increased plant biomass, leaf RWC, and osmotolerant proline content under drought stress [34]. Additionally, although the drought-tolerant effects of other species are unknown, the salt stress-ameliorating effects of K. cowanii and P. ananatis have been reported previously [35,36].
Notably, the beneficial effects of seed bacteria were manifested mostly in genotype P3, and the same bacterial strains had neutral or even negative effects on the growth of other plant genotypes. Previous studies have reported contrasting results regarding the effects of plant genotypes. For instance, A. thaliana accessions showed variable responses in shoot and root development when applying volatile organic compounds produced by Pseudomonas simiae [37]. Additionally, wheat cultivars infected with Paenibacillus sp. show differential resistance to pathogens [20]. In contrast, Pseudomonas sp. and Methylorubrum sp. isolated from rice seeds show similar growth-promoting activities in the two rice cultivars [21]. Our results support the hypothesis that the effects of endophytic bacteria depend on the plant genotype.
Suppose that drought tolerance is one of the critical attributes for the invasive success of L. serriola. In that case, seed bacteria can facilitate the invasion of some genotypes by promoting plant performance under drought conditions, but they can also hinder the invasion of other genotypes. This suggests that the interaction between plants and seed bacteria should be assessed with respect to the genotype of host plants to evaluate the ecological significance of seed bacteria. Given the diverse effects on plant performance [1,3,11], it is questionable whether bacterial strains with adverse impacts on the plant performance in dry conditions also have negative effects in different environmental conditions. Examining plant-microbe interactions in diverse environmental conditions is required for a more complete understanding of the role of seed bacteria in invasive success.
4.2. Effects of Bacterial Infection on Rhizosphere Characteristics
Isolates that were used to infect L. serriola seeds successfully colonized the rhizosphere, as confirmed by the isolation of GFPuv-expressing colonies from root tissue and microscopic observation. The confocal images showed that the isolates colonized both the root surface and endosphere, indicating that the isolates also colonized the surrounding environments [38]. These bacteria can potentially manipulate the rhizosphere microenvironment.
In this study, the RDPI for soil water content was positively correlated with the RDPI for plant biomass and RAS quantity across bacterial treatments and plant genotypes. Given that a thick rhizosheath can ameliorate drought stress [16,17], the bacterial infection and plant genotype might affect the RAS quantity together, consequently influencing soil water content and biomass production under drought conditions.
The quantity of RAS is highly dependent on root hairs and adhesive mucilage, of which polysaccharides constitute the major component [39]. Bacteria in the rhizosphere can produce exopolysaccharides for their own protection in extreme environments [22]. As a side effect, extracellular polysaccharides can aggregate soil particles, increase the amount of RAS, and facilitate water retention under drought conditions [40]. P. ananatis GG19 and K. cowanii YJ4 and SD1 strains can produce more exopolysaccharides when exposed to high osmotic pressure [10]. When they colonized the rhizosphere of the P3 genotype plants, their exopolysaccharide production might have contributed to the formation of RAS and induced higher drought tolerance.
Suppose that bacterial production of exopolysaccharides is a major mechanism for promoting RAS formation. In that case, the degree of bacterial colonization on the root surface is expected to correlate with the RAS quantity. Although the colonization ability could not be measured quantitatively, the confocal microscopy suggested that K. cowanii GG1 and P. ananatis GG19 seemed to colonize in the root surface of the P1 genotype more than other testing strains (Figure 3). Notably, contrasting plastic responses of plants to those two strains were observed. The P1 genotype rarely responded to the infection of P. ananatis GG19, but it exhibited negative RDPI of the biomass production in response to K. cowanii GG1, similar to plants infected by C. dublienesis MS26 (Figure 4). This result suggests that factors other than exopolysaccharide production likely contribute to the RAS production.
Bacterial production of phytohormones can influence RAS quantity. All tested bacterial strains, except K. cowanii GG1, can produce both indole acetic acid and 1-aminocyclopropane-1-carboxylate (ACC) deaminase, which can modulate the levels of phytohormones [10]. Production of indole acetic acid by plant-associated bacteria can stimulate root hair development [41], which possibly increases the RAS quantity. Furthermore, reduced ethylene levels by ACC deaminase can promote the production of RAS [42].
In addition, the inoculated bacteria themselves might not be involved in the changes in soil characteristics. Instead, inoculated bacteria might alter the microbial community in the rhizosphere, which might stimulate the formation of RAS and increase soil water contents. For instance, applying the Paenibacillus strain to lettuce plants induced the resistance to soil pathogen not directly but indirectly by shifting microbial community in the rhizosphere [43]. In a similar way, inoculated bacteria might increase other bacteria in the rhizosphere that have the ability to alleviate drought stress. Next-generation sequencing of root endosphere and rhizosphere can provide information to test this hypothesis [43].
The colonization and functional traits of plant-associated rhizobacteria are widely known to be affected by the composition of root exudates from the host plants [44,45,46]. Because the bacterial strains in this study colonized the rhizosphere (Figure 3 and Figure S1), their genotype-specific effects might be due to the difference in root exudate compounds among plant genotypes. Root exudates can regulate gene expression of plant-associated bacteria related to diverse metabolic pathways and stress responses [47]. Variation in root exudates might modulate the production of exopolysaccharides and phytohormones in testing bacterial strains or other bacteria in the rhizosphere, which might induce genotype-specific biomass production under drought conditions. Transcriptome analysis of the host plant and isolates can provide more information about the stress ameliorating mechanism of isolates [48,49].
In conclusion, bacteria isolated from the seeds of L. serriola can exert beneficial effects on their origin under drought stress; however, the effects depend on the plant genotype. Both plant genotype and bacterial strain influenced the quantity of root-adhering soil, correlating with plant performance and soil water contents. These results imply that plant genotype is a determining factor in the contribution of symbiotic seed bacteria to drought tolerance, a critical attribute for the invasive success of L. serriola.
Supplementary Materials
The following supporting information can be downloaded at: https://www.mdpi.com/article/10.3390/microorganisms10081604/s1, Figure S1: Images of the root tissues of Lactuca serriola genotype P5 with GFPuv-transformed isolates using confocal microscopy. Table S1. Sample size for each bacterial treatment and each plant genotype.
Author Contributions
Conceptualization, S.J. and E.K.; methodology, validation and investigation, S.J., T.-M.K., B.C., Y.K. and H.K.; software, formal analysis, data curation, writing—original draft and visualization, S.J.; resources, supervision, project administration and funding acquisition, writing—review and editing, E.K. All authors have read and agreed to the published version of the manuscript.
Funding
This research was supported by the Basic Science Research Program through the National Research Foundation of Korea (NRF) funded by the Ministry of Education, grant number 2021R1I1A2047635.
Institutional Review Board Statement
Not applicable.
Informed Consent Statement
Not applicable.
Data Availability Statement
All data is included in the manuscript.
Acknowledgments
The authors thank Hor-Gil Hur, Hansoo Park and Kee Dae Kim for their insightful comments. We also thank GIST Central Research Facility for the equipment support of CLSM FV3000RS.
Conflicts of Interest
The authors declare no conflict of interest. The funders had no role in the design of the study; in the collection, analyses, or interpretation of data; in the writing of the manuscript, or in the decision to publish the results.
References
- Lyu, D.; Zajonc, J.; Pagé, A.; Tanney, C.A.; Shah, A.; Monjezi, N.; Msimbira, L.A.; Antar, M.; Nazari, M.; Backer, R. Plant holobiont theory: The phytomicrobiome plays a central role in evolution and success. Microorganisms 2021, 9, 675. [Google Scholar] [CrossRef]
- Vandenkoornhuyse, P.; Quaiser, A.; Duhamel, M.; Le Van, A.; Dufresne, A. The importance of the microbiome of the plant holobiont. New Phytol. 2015, 206, 1196–1206. [Google Scholar] [CrossRef]
- Egamberdieva, D.; Wirth, S.J.; Alqarawi, A.A.; Abd_Allah, E.F.; Hashem, A. Phytohormones and beneficial microbes: Essential components for plants to balance stress and fitness. Front. Microbiol. 2017, 8, 2104. [Google Scholar] [CrossRef]
- Ferreira, M.J.; Silva, H.; Cunha, A. Siderophore-producing rhizobacteria as a promising tool for empowering plants to cope with iron limitation in saline soils: A review. Pedosphere 2019, 29, 409–420. [Google Scholar] [CrossRef]
- Vaishnav, A.; Shukla, A.K.; Sharma, A.; Kumar, R.; Choudhary, D.K. Endophytic bacteria in plant salt stress tolerance: Current and future prospects. J. Plant Growth Regul. 2019, 38, 650–668. [Google Scholar] [CrossRef]
- Chandra, P.; Wunnava, A.; Verma, P.; Chandra, A.; Sharma, R.K. Strategies to mitigate the adverse effect of drought stress on crop plants—Influences of soil bacteria: A review. Pedosphere 2021, 31, 496–509. [Google Scholar] [CrossRef]
- Elsheikh, E.A.; El-Keblawy, A.; Mosa, K.A.; Okoh, A.I.; Saadoun, I. Role of endophytes and rhizosphere microbes in promoting the invasion of exotic plants in arid and semi-arid areas: A review. Sustainability 2021, 13, 13081. [Google Scholar] [CrossRef]
- White, J.F.; Kingsley, K.I.; Kowalski, K.P.; Irizarry, I.; Micci, A.; Soares, M.A.; Bergen, M.S. Disease protection and allelopathic interactions of seed-transmitted endophytic pseudomonads of invasive reed grass (Phragmites australis). Plant Soil 2018, 422, 195–208. [Google Scholar] [CrossRef]
- Mateu, M.G.; Baldwin, A.H.; Maul, J.E.; Yarwood, S.A. Dark septate endophyte improves salt tolerance of native and invasive lineages of Phragmites australis. ISME J. 2020, 14, 1943–1954. [Google Scholar] [CrossRef]
- Jeong, S.; Kim, T.-M.; Choi, B.; Kim, Y.; Kim, E. Invasive Lactuca serriola seeds contain endophytic bacteria that contribute to drought tolerance. Sci. Rep. 2021, 11, 13307. [Google Scholar] [CrossRef]
- Truyens, S.; Weyens, N.; Cuypers, A.; Vangronsveld, J. Bacterial seed endophytes: Genera, vertical transmission and interaction with plants. Environ. Microbiol. Rep. 2015, 7, 40–50. [Google Scholar] [CrossRef]
- Kim, Y.-H.; Kil, J.-H.; Hwang, S.-M.; Lee, C.-W. Spreading and distribution of Lactuca scariola, invasive alien plant, by habitat types in Korea. Weed Turfgrass Sci. 2013, 2, 138–151. [Google Scholar] [CrossRef]
- Xie, L.; Lehvävirta, S.; Timonen, S.; Kasurinen, J.; Niemikapee, J.; Valkonen, J.P. Species-specific synergistic effects of two plant growth—Promoting microbes on green roof plant biomass and photosynthetic efficiency. PLoS ONE 2018, 13, e0209432. [Google Scholar] [CrossRef] [PubMed]
- Long, H.H.; Schmidt, D.D.; Baldwin, I.T. Native bacterial endophytes promote host growth in a species-specific manner; phytohormone manipulations do not result in common growth responses. PLoS ONE 2008, 3, e2702. [Google Scholar] [CrossRef] [Green Version]
- Sandhya, V.; Grover, M.; Reddy, G.; Venkateswarlu, B. Alleviation of drought stress effects in sunflower seedlings by the exopolysaccharides producing Pseudomonas putida strain GAP-P45. Biol. Fertil. Soils 2009, 46, 17–26. [Google Scholar] [CrossRef]
- Watt, M.; McCully, M.E.; Canny, M.J. Formation and stabilization of rhizosheaths of Zea mays L. (effect of soil water content). Plant Physiol. 1994, 106, 179–186. [Google Scholar] [CrossRef] [Green Version]
- Liu, T.Y.; Ye, N.; Song, T.; Cao, Y.; Gao, B.; Zhang, D.; Zhu, F.; Chen, M.; Zhang, Y.; Xu, W. Rhizosheath formation and involvement in foxtail millet (Setaria italica) root growth under drought stress. J. Integr. Plant Biol. 2019, 61, 449–462. [Google Scholar] [CrossRef]
- Liu, Y.; Zuo, S.; Xu, L.; Zou, Y.; Song, W. Study on diversity of endophytic bacterial communities in seeds of hybrid maize and their parental lines. Arch. Microbiol. 2012, 194, 1001–1012. [Google Scholar] [CrossRef]
- Xu, M.; Sheng, J.; Chen, L.; Men, Y.; Gan, L.; Guo, S.; Shen, L. Bacterial community compositions of tomato (Lycopersicum esculentum Mill.) seeds and plant growth promoting activity of ACC deaminase producing Bacillus subtilis (HYT-12-1) on tomato seedlings. World J. Microbiol. Biotechnol. 2014, 30, 835–845. [Google Scholar] [CrossRef] [PubMed]
- Samain, E.; Aussenac, T.; Selim, S. The effect of plant genotype, growth stage, and Mycosphaerella graminicola strains on the efficiency and durability of wheat-induced resistance by Paenibacillus sp. Strain B2. Front. Plant Sci. 2019, 10, 587. [Google Scholar] [CrossRef] [PubMed] [Green Version]
- Krishnamoorthy, A.; Agarwal, T.; Kotamreddy, J.N.R.; Bhattacharya, R.; Mitra, A.; Maiti, T.K.; Maiti, M.K. Impact of seed-transmitted endophytic bacteria on intra-and inter-cultivar plant growth promotion modulated by certain sets of metabolites in rice crop. Microbiol. Res. 2020, 241, 126582. [Google Scholar] [CrossRef] [PubMed]
- Bhagat, N.; Raghav, M.; Dubey, S.; Bedi, N. Bacterial exopolysaccharides: Insight into their role in plant abiotic stress tolerance. J. Microbiol. Biotechnol. 2021, 31, 1045–1059. [Google Scholar] [CrossRef] [PubMed]
- Wang, K.; Kang, L.; Anand, A.; Lazarovits, G.; Mysore, K.S. Monitoring in planta bacterial infection at both cellular and whole-plant levels using the green fluorescent protein variant GFPuv. New Phytol. 2007, 174, 212–223. [Google Scholar] [CrossRef] [PubMed]
- Yahaghi, Z.; Shirvani, M.; Nourbakhsh, F.; Pueyo, J.J. Uptake and effects of lead and zinc on alfalfa (Medicago sativa L.) seed germination and seedling growth: Role of plant growth promoting bacteria. S. Afr. J. Bot. 2019, 124, 573–582. [Google Scholar] [CrossRef]
- Huang, X.-F.; Zhou, D.; Lapsansky, E.R.; Reardon, K.F.; Guo, J.; Andales, M.J.; Vivanco, J.M.; Manter, D.K. Mitsuaria sp. and Burkholderia sp. from Arabidopsis rhizosphere enhance drought tolerance in Arabidopsis thaliana and maize (Zea mays L.). Plant Soil 2017, 419, 523–539. [Google Scholar] [CrossRef]
- Sharma, M.; Pang, J.; Wen, Z.; De Borda, A.; Kim, H.S.; Liu, Y.; Lambers, H.; Ryan, M.H.; Siddique, K.H. A significant increase in rhizosheath carboxylates and greater specific root length in response to terminal drought is associated with greater relative phosphorus acquisition in chickpea. Plant Soil 2021, 460, 51–68. [Google Scholar] [CrossRef]
- Türkan, I.; Bor, M.; Özdemir, F.; Koca, H. Differential responses of lipid peroxidation and antioxidants in the leaves of drought-tolerant P. acutifolius Gray and drought-sensitive P. vulgaris L. subjected to polyethylene glycol mediated water stress. Plant Sci. 2005, 168, 223–231. [Google Scholar] [CrossRef]
- Zhang, Z.; Huang, R. Analysis of malondialdehyde, chlorophyll proline, soluble sugar, and glutathione content in Arabidopsis seedling. Bio-Protocol 2013, 3, e817. [Google Scholar] [CrossRef]
- Rao, K.M.; Sresty, T. Antioxidative parameters in the seedlings of pigeonpea (Cajanus cajan (L.) Millspaugh) in response to Zn and Ni stresses. Plant Sci. 2000, 157, 113–128. [Google Scholar]
- Safařík, I.; Šantrůčková, H. Direct determination of total soil carbohydrate content. Plant Soil 1992, 143, 109–114. [Google Scholar] [CrossRef]
- Kurihara, D.; Mizuta, Y.; Sato, Y.; Higashiyama, T. ClearSee: A rapid optical clearing reagent for whole-plant fluorescence imaging. Development 2015, 142, 4168–4179. [Google Scholar] [CrossRef] [Green Version]
- Ursache, R.; Andersen, T.G.; Marhavý, P.; Geldner, N. A protocol for combining fluorescent proteins with histological stains for diverse cell wall components. Plant J. 2018, 93, 399–412. [Google Scholar] [CrossRef] [PubMed] [Green Version]
- Valladares, F.; Sanchez-Gomez, D.; Zavala, M.A. Quantitative estimation of phenotypic plasticity: Bridging the gap between the evolutionary concept and its ecological applications. J. Ecol. 2006, 94, 1103–1116. [Google Scholar] [CrossRef]
- Manjunatha, B.S.; Nivetha, N.; Krishna, G.K.; Elangovan, A.; Pushkar, S.; Chandrashekar, N.; Aggarwal, C.; Asha, A.D.; Chinnusamy, V.; Raipuria, R.K. Plant growth-promoting rhizobacteria Shewanella putrefaciens and Cronobacter dublinensis enhance drought tolerance of pearl millet by modulating hormones and stress-responsive genes. Physiol. Plant. 2022, 174, e13676. [Google Scholar] [CrossRef]
- Lu, L.; Chang, M.; Han, X.; Wang, Q.; Wang, J.; Yang, H.; Guan, Q.; Dai, S. Beneficial effects of endophytic Pantoea ananatis with ability to promote rice growth under saline stress. J. Appl. Microbiol. 2021, 131, 1919–1931. [Google Scholar] [CrossRef] [PubMed]
- Noori, F.; Etesami, H.; Zarini, H.N.; Khoshkholgh-Sima, N.A.; Salekdeh, G.H.; Alishahi, F. Mining alfalfa (Medicago sativa L.) nodules for salinity tolerant non-rhizobial bacteria to improve growth of alfalfa under salinity stress. Ecotoxicol. Environ. Saf. 2018, 162, 129–138. [Google Scholar] [CrossRef] [PubMed]
- Wintermans, P.C.; Bakker, P.A.; Pieterse, C.M. Natural genetic variation in Arabidopsis for responsiveness to plant growth-promoting rhizobacteria. Plant Mol. Biol. 2016, 90, 623–634. [Google Scholar] [CrossRef] [Green Version]
- Fadiji, A.E.; Babalola, O.O. Exploring the potentialities of beneficial endophytes for improved plant growth. Saudi J. Biol. Sci. 2020, 27, 3622–3633. [Google Scholar] [CrossRef]
- Galloway, A.F.; Akhtar, J.; Marcus, S.E.; Fletcher, N.; Field, K.; Knox, P. Cereal root exudates contain highly structurally complex polysaccharides with soil-binding properties. Plant J. 2020, 103, 1666–1678. [Google Scholar] [CrossRef]
- Costa, O.Y.; Raaijmakers, J.M.; Kuramae, E.E. Microbial extracellular polymeric substances: Ecological function and impact on soil aggregation. Front. Microbiol. 2018, 9, 1636. [Google Scholar] [CrossRef] [Green Version]
- Spaepen, S.; Dobbelaere, S.; Croonenborghs, A.; Vanderleyden, J. Effects of Azospirillum brasilense indole-3-acetic acid production on inoculated wheat plants. Plant Soil 2008, 312, 15–23. [Google Scholar] [CrossRef]
- Zhang, Y.; Du, H.; Xu, F.; Ding, Y.; Gui, Y.; Zhang, J.; Xu, W. Root-bacteria associations boost rhizosheath formation in moderately dry soil through ethylene responses. Plant Physiol. 2020, 183, 780–792. [Google Scholar] [CrossRef] [PubMed]
- Passera, A.; Vacchini, V.; Cocetta, G.; Shahzad, G.-I.-R.; Arpanahi, A.A.; Casati, P.; Ferrante, A.; Piazza, L. Toward nutrition-sensitive agriculture: An evaluation of biocontrol effects, nutritional value, and ecological impact of bacterial inoculants. Sci. Total Environ. 2020, 724, 138127. [Google Scholar] [CrossRef] [PubMed]
- Zhang, N.; Wang, D.; Liu, Y.; Li, S.; Shen, Q.; Zhang, R. Effects of different plant root exudates and their organic acid components on chemotaxis, biofilm formation and colonization by beneficial rhizosphere-associated bacterial strains. Plant Soil 2014, 374, 689–700. [Google Scholar] [CrossRef]
- Micallef, S.A.; Shiaris, M.P.; Colón-Carmona, A. Influence of Arabidopsis thaliana accessions on rhizobacterial communities and natural variation in root exudates. J. Exp. Bot. 2009, 60, 1729–1742. [Google Scholar] [CrossRef] [Green Version]
- Vacheron, J.; Desbrosses, G.; Bouffaud, M.-L.; Touraine, B.; Moënne-Loccoz, Y.; Muller, D.; Legendre, L.; Wisniewski-Dyé, F.; Prigent-Combaret, C. Plant growth-promoting rhizobacteria and root system functioning. Front. Plant Sci. 2013, 4, 356. [Google Scholar] [CrossRef] [Green Version]
- Mavrodi, O.V.; McWilliams, J.R.; Peter, J.O.; Berim, A.; Hassan, K.A.; Elbourne, L.D.; LeTourneau, M.K.; Gang, D.R.; Paulsen, I.T.; Weller, D.M. Root exudates alter the expression of diverse metabolic, transport, regulatory, and stress response genes in rhizosphere Pseudomonas. Front. Microbiol. 2021, 12, 698. [Google Scholar] [CrossRef]
- Rawoof, A.; Ramchiary, N.; Abdin, M.Z. A high-throughput RNA-Seq approach to elucidate the transcriptional response of Piriformospora indica to high salt stress. Sci. Rep. 2021, 11, 4129. [Google Scholar]
- Dinkins, R.D.; Nagabhyru, P.; Young, C.A.; West, C.P.; Schardl, C.L. Transcriptome analysis and differential expression in tall fescue harboring different endophyte strains in response to water deficit. Plant Genome 2019, 12, 180071. [Google Scholar] [CrossRef] [Green Version]
Publisher’s Note: MDPI stays neutral with regard to jurisdictional claims in published maps and institutional affiliations. |
© 2022 by the authors. Licensee MDPI, Basel, Switzerland. This article is an open access article distributed under the terms and conditions of the Creative Commons Attribution (CC BY) license (https://creativecommons.org/licenses/by/4.0/).